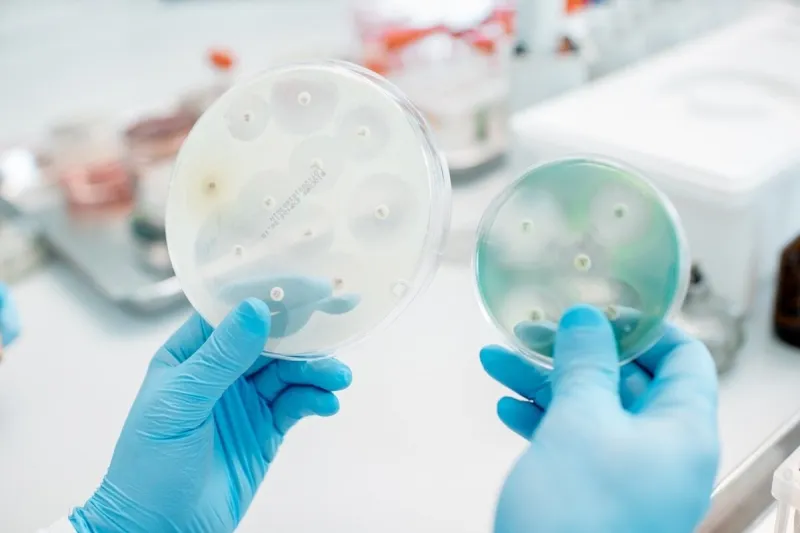
WHO začala monitorovať nový variant koronavírusu - Svet SME

Koronavírus
- Filter:
- všetko
- Igor Matovič (104x)
- Eduard Heger (64x)
- Richard Sulík (38x)
- Veronika Remišová (28x)
- Zuzana Čaputová (27x)
- Peter Pellegrini (15x)
- Matúš Vallo (11x)
- Andrej Danko (9x)
- Roman Mikulec (9x)
- Boris Kollár (8x)
- Robert Fico (6x)
- Vladimír Pčolinský (5x)
- Šutaj Eštok (4x)
- Zuzana Plačková (3x)
- Peter Kotlár (2x)
- Robert Kaliňák (2x)
- Lucia Žitňanská (2x)
- Jaroslav Naď (2x)
- Maroš Žilinka (2x)
- Lucia Ďuriš Nicholsonová (2x)
- Milan Majerský (1x)
- Tomáš Drucker (1x)
- Alojz Hlina (1x)
- Jaroslav Paška (1x)
- Iveta Radičová (1x)
- Denisa Saková (1x)
 cas.sk
cas.sk
02.09.2021
Lászla Bénesa čaká od futbalu prestávka: Vyšiel mu pozitívny test na koronavírus, hoci je voči nemu zaočkovaný!
 topky.sk
topky.sk
02.09.2021
KORONAVÍRUS V Rakúsku si berú príklad zo Slovenska: Za očkovanie môžu vyhrať víno, ale aj auto
 topky.sk
topky.sk
01.09.2021
KORONAVÍRUS Povinné očkovanie zdravotníkov v Grécku: Približne 10-tisíc ľudí môže prísť o prácu
 tyzden.sk
tyzden.sk
01.09.2021
Na Slovensku pribudlo 199 prípadov nákazy novým koronavírusom
 ta3.com
ta3.com
01.09.2021
Unikli údaje tisícok ľudí testovaných na koronavírus. Začalo sa vyšetrovanie - TA3
 dnes24.sk
dnes24.sk
01.09.2021
Koronavírus naberá na sile: Na Slovensku pribudlo takmer DVESTO nových prípadov
 www.sme.sk
www.sme.sk
01.09.2021
WHO začala monitorovať nový variant koronavírusu - Svet SME
 topky.sk
topky.sk
01.09.2021
KORONAVÍRUS v Maďarsku: Školský rok sa začal prezenčne, zmiernili epidemiologické opatrenia
 webnoviny.sk
webnoviny.sk
01.09.2021
Izrael napriek prudkému nárastu počtu nakazených koronavírusom otvoril nový školský rok - vSkolstve.sk
 topky.sk
topky.sk
01.09.2021
KORONAVÍRUS WHO má obavy: Monitoruje TENTO variant covidu, môže uniknúť imunitnému systému
 teraz.sk
teraz.sk
01.09.2021
Kapitán Švajčiarska Xhaka mal pozitívny test na koronavírus
 teraz.sk
teraz.sk
01.09.2021
Na Slovensku pribudlo 199 prípadov nákazy novým koronavírusom
 domov.sme.sk
domov.sme.sk
01.09.2021
Koronavírus na Slovensku: Pribudlo 199 prípadov a žiadne úmrtie na Covid-19 - SME
 topky.sk
topky.sk
01.09.2021
Únik osobných údajov pozitívne testovaných na KORONAVÍRUS: Rakúske úrady incident vyšetrujú
 webnoviny.sk
webnoviny.sk
01.09.2021
Akciový trh v USA uzavrel zmiešane, koronavírus možno utlmuje ekonomickú aktivitu v krajine - voFinanciach.sk
 topky.sk
topky.sk
01.09.2021
KORONAVÍRUS Lengvarský hovorí o aktuálnej situácii stále ako o dobrej: MAPA aktuálnych farieb okresov
Hľadanie
- Kauza bankomatová mafia
- David Lindtner
- Peter Kotlár
- Prípad prokurátora Šúreka
- Zrušenie špeciálnej prokuratúry
- Kauza AllatRa
- Milan Lučanský
- Ruský plyn
- Šimečkova matka
- Havárie vlakov na Slovensku
- Kauza Ducký
- Kauza eurofondy na vedu
- Happy Travel
- Únos Babiša na Krym
- Sudca Truban
- Záchrankový tender
- Kauza Judáš
- Akcia Valentín
- Akcia Funeral
- Kauza Čurillovci
- Vojenská pomoc Ukrajine
- Úprava hymny
- Dve pohlavia v ústave
- Objednávka vraždy Sylvie Volzovej
- Šimkovičovej pracovná cesta v USA
- Marek Para
- Šéf SIS mal dopravnú nehodu
- Kauza korupcie Jankovskej - Fatima
- Peter Kažimír
- Kauza Syseľ